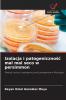
Izolacja i patogeniczność mal mal seco w persimmon

Polish
Paperback
₹5334
(All inclusive*)
Delivery Options
Please enter pincode to check delivery time.
*COD & Shipping Charges may apply on certain items.
Review final details at checkout.
Looking to place a bulk order? SUBMIT DETAILS
About The Book
Description
Author
Quequisque jest rodzajem rośliny zielnej jednorocznego typu produkcyjnego jej jedzenie zawiera silną koncentrację węglowodanów i jest uprawą o dużym znaczeniu gospodarczym dla nikaraguańskich producentów którzy zajmują się tą uprawą głównie na małych obszarach zlokalizowanych głównie w Autonomicznym Regionie Południowego Wybrzeża Karaibskiego Nikaragui (RACCS) Jednak uprawy te zostały silnie dotknięte chorobą Mal seco która rozprzestrzenia się głównie poprzez przemieszczanie gleby i materiału roślinnego skażonego patogenem który do tej pory został zidentyfikowany jako Pythium myriotylum . Metodologia zwykle stosowana w Nikaragui do izolacji P. myriotylum jest bardzo pracochłonna co prowadzi do poszukiwania bardziej praktycznych metod i selektywnych podłoży hodowlanych w celu uzyskania czystych kultur.
Delivery Options
Please enter pincode to check delivery time.
*COD & Shipping Charges may apply on certain items.
Review final details at checkout.
Details
ISBN 13
9786208763824
Publication Date
-20-03-2025
Pages
-60
Weight
-95 grams
Dimensions
-152x229x3.65 mm